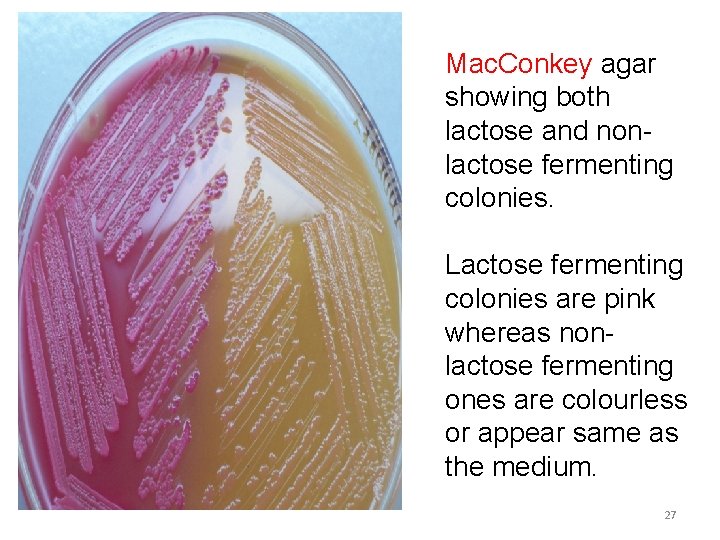
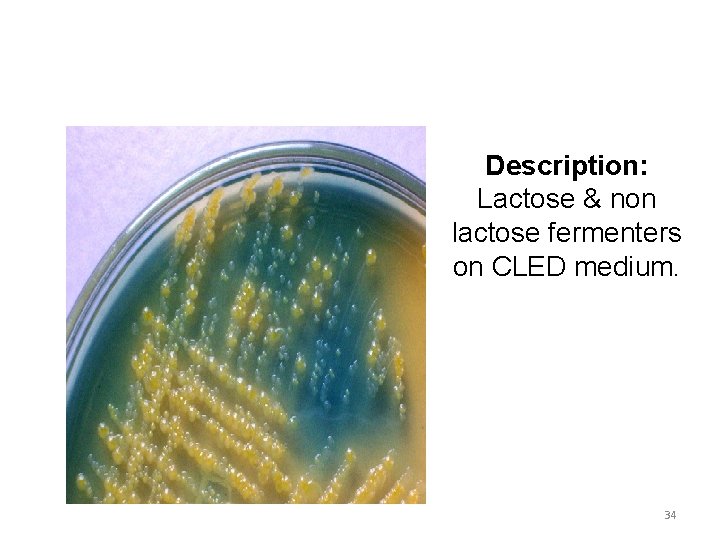

culture media 1 CULTURE AND THE MEDIUM CULTURE










































- Slides: 42

culture media 1

CULTURE AND THE MEDIUM • CULTURE : Is the term given to microorganisms that are cultivated in the lab for the purpose of identifying and studying them. 2

• MEDIUM: Is the term given to the combination of ingredients that will support the growth and cultivation of microorganisms by providing all the essential nutrients required for the growth (i. e. multiplication) in order to cultivate these microorganisms in large number to study them. 3

• Microbiological culture: which are used for growing microorganisms, such as bacteria or yeast. • The most common growth media for microorganisms are nutrient broths and agar plates • Specialized media are sometimes required for microorganism and cell culture growth. 4

CULTURE MEDIA • Used to grow bacteria • Can be used tov Enrich the numbers of bacteria. v Select for certain bacteria and suppress others. v Differentiate among different kinds of bacteria. 5

NEED FOR CULTURE MEDIA • It is usually essential to obtain a culture by growing the organism in an artificial medium. • If more than one species or type of organism are present each requires to be carefully separated or isolated in pure culture. 11/9/2020 6

BASIC REQUIREMENTS OF CULTURE MEDIA • NUTRIENTS : q Energy source q Carbon source q Nitrogen source • MINERAL SALTS : q Sulphates, phosphates, chlorides and carbonates of K, Mg and Ca q A suitable p. H- 7. 2 - 7. 4 7

GROWTH FACTORS ARGININE E. COLI GLUTATHIONE GONOCOCCI CHOLESTEROL MYCOPLASMA ARYL SULPHATE, AMIDE ATYPICAL MYCOBACTERIA GLYCEROL MYCOPLASMA HOMINIS SULFONAMIDES RIKETTSIA TRYPTOPHAN SALMONELLA TYPHI L-CYSTEINE LISTERIA MONOCYTOGENS SODIUM CHLORIDE VIBRIO PARAHAEMOLYTICUS 11/9/2020 FACTOR X & V H. INFLUENZAE 8

CLASSIFICATION BASED ON PHYSICAL STATE BASED ON PRESENCE OF MOLECULAR OXYGEN AND REDUCING SUBSTANCES BASED ON NUTRITIONAL FACTORS LIQUID MEDIA AEROBIC MEDIA SIMPLE MEDIA SEMISOLID MEDIA ANAEROBIC MEDIA COMPLEX MEDIA SOLID MEDIA SYNTHETIC MEDIA SPECIAL MEDIA 9

SPECIAL MEDIA A. ENRICHED MEDIA B. ENRICHMENT MEDIA C. SELECTIVE MEDIA D. DIFFERENTIAL MEDIA E. INDICATOR MEDIA F. TRANSPORT MEDIA G. SUGAR MEDIA 10

SIMPLE MEDIA Simple or basal media are culture media which contain the minimum adequate nutrition for non fastidious organisms Example: - Nutrient broth/agar Peptone water Composition: Lab-Lemco -10 gm peptone-10 gm Na. Cl- 5 gm Distilled water-1000 ml - - For semisolid media – agar concentration is 0. 2 -0. 4% When 2 -3% agar is added , then we have it as nutrient agar. Uses: 1. This is basis of most of the media used in the study at common pathogenic bacteria. 2. It is used for subcultures of certain organisms.

NUTRIENT AGAR NUTRIENT BROTH

PEPTONE WATER • TYPE : Basic liquid media • APPEARANCE : clear, colorless, watery, usually in test tube • Composition : PEPTONE 10 g SODIUM CHLORIDE, Na. Cl 5 g WATER 1 litre 13

USES OF PEPTONE WATER Ø The media is used chiefly as the basis for carbohydrate fermentation media. Ø Nutrient broths may contain a small amount of sugar derived from meat and it is essential that the basal medium to which various carbohydrates are added for fermentation tests should be free from natural sugars. 11/9/2020 14

üIt is also used to test the formation of indole. üCulture of organisms for demonstration of motility 11/9/2020 15

COMPLEX MEDIA Complex media have added ingredients for bringing out certain properties or providing special nutrients required for growth of the bacterium in question. SYNTHETIC MEDIA ü These are prepared from pure chemicals and the exact compositions of medium is very well known. Example : - Dubo’s medium SEMIDEFINED MEDIA ü In these media the exact chemical composition of the constituents is not known because substances like meat and peptone are used. ü Most of the culture media used for routine diagnostic work are semidefined culture media.

SPECIAL MEDIUM • ENRICHED MEDIA When basal medium is added with some nutrients such as blood, serum or egg is called enriched media. v They are used to grow bacteria which are more exacting in their nutritional needs. Examples: Dorset’s Egg Medium. ü It is a creamy coloured opaque slope kept in screw copped bottle ü Selective medium for isolation of Mycobacterium tuberculosis. ü Composition: Hen’s egg, Nutrient broth v

BLOOD AGAR • TYPE : Enriched media. • APPEARANCE : Red color. • COMPOSITION : Sterile Nutrient agar + Defibrinated sheep blood USES : v Routine culture v Widely used in medical bacteriology v It is also an indicator medium showing the haemolytic properties of bacteria such as Streptococcus pyogenes. 18

CHOCOLATE AGAR Also called Heated blood agar. • TYPE : Enriched media. • APPEARANCE : Chocolate brown color. PROCEDURE Melt the desired amount of nutrient agar. Cool it in a water – bath at 75º C. Add 10 ml of sterile blood. Allow the medium to remain at 75º C. 19

Mixing the blood and agar by gentle agitation from time to time until the blood become chocolate brown in color, within about 10 min. Then pour in plates. USES ü CULTURE OF Neisseria ü CULTURE OF Haemophilus influenzae ü CULTURE OF Pneumococcus 20

ENRICHMENT MEDIA v In this media, it has a stimulating effect on the bacteria to be grown or inhibits competitors. v This result in an absolute increase in the number of wanted bacteria related to other bacteria. v Example: - Selenite F broth ü It is enrichment medium for culture of Salmonella typhi and paratyphi bacilli from stool sample ü Principle: - at neutral p. H solution acid salinity has high toxicity to coli form group of bacteria and not to most of the salmonella groups.

SELENITE F BROTH Alkaline peptone water

SELECTIVE MEDIA v It is a medium in which certain substances are present which inhibit all other bacteria except the desired bacteria. v It encourages the growth of particular species from a mixed inoculum. Example: - TCBS -It is light green translucent medium kept in petridish -It is selective medium for Vibrio cholera -Principle: Bile salt inhibit the growth of normal commensals (unwanted bacteria). ü Vibrio chloerae produce acid by fermentation of sucrose which acts on bromothymol blue (indicator) producing yellow colonies.

Salmonella Shigella Agar with DCA Salmonella-Shigella agar plate (SS)

DIFFERENTIAL MEDIA 11/9/2020 25

MAC CONKEY AGAR • Mac. Conkey agar is a culture medium designed to grow Gram-negative bacteria. It is a useful medium for the cultivation of enterobacteriacea. 26
Mac. Conkey agar showing both lactose and nonlactose fermenting colonies. Lactose fermenting colonies are pink whereas nonlactose fermenting ones are colourless or appear same as the medium. 27

• It contains lactose and neutral red to distinguish the lactose- fermenting coliforms from the lactose non –fermenting salmonella and shigella groups. 28

• It contains Bile salts to inhibit non-intestinal bacteria and most Gram-positive bacteria, except Enterococcus and some species of Staphylococcus i. e. Staphylococcus aureus. • Neutral red dye : which stains microbes fermenting lactose. • Crystal violet dye : which also inhibits certain Gram-positive bacteria). 29

• Gram-negative bacteria growing on the media are differentiated by their ability to ferment the sugar lactose. • Lactose fermenter cause the p. H to drop and is detected by neutral red, (red at p. H's below 6. 8. ) which appear as bright pink to red colonies on the agar. 30

• Uses • Acting as a visual p. H indicator, the agar distinguishes those Gram-negative bacteria that can ferment the sugar lactose (Lac+) from those that cannot (Lac-). v. This medium is also known as an • "indicator medium" • "low selective medium". • Absence of electrolytes serves to inhibit swarming by Proteus species 31

Lac+ • By utilizing the lactose available in the medium, Lac+ bacteria such as Ø Escherichia coli Ø Enterobacter spp. Ø Klebsiella spp. will produce acid, which lowers the p. H of the agar below 6. 8 and results in the appearance of red/pink colonies 32

CLED (Cystine Lactose Electrolyte Deficient medium) • It is a valuable non-inhibitory growth medium used in the isolation and differentiation of urinary organisms. • Being electrolyte deficient, it prevents the swarming of Proteus species 33
Description: Lactose & non lactose fermenters on CLED medium. 34

INDICATOR MEDIUM v These media contain an indicator which changes colour when bacteria grow on them. v Example: - Wilson and Blair medium ü For isolation of Salmonella typhi and S. paratyphi ü They appear as black colonies ü Principle: - The black colour of colonies is due to the ability of these organisms to reduce bismuth sulphite to sulphide in the presence of glucose coliforms are inhibited by brilliant green and bismuth sullphite

TRANSPORT MEDIUM üThese are used for the temporary storage of specimens being transported to the laboratory for cultivation. üSuch media ideally maintain the viability of all organisms in the specimen without altering their concentration. üTransport media typically contain only buffers and salt. üThe lack of carbon, nitrogen, and organic growth factors prevents microbial multiplication. üTransport media used in the isolation of anaerobes must be free of molecular oxygen. STUART TRANSPORT BROTH

CHARACTERISTICS OF TRANSPORT MEDIA: • • • It should be non-toxic It should not promote or inhibit the bacterial growth It should be easy to carry and transport Examples: 1. Venkatraman Ramakrishnan medium 2. Buffered glycerol saline transport medium 3. Cary and Blair medium

ANAEROBIC MEDIUM These media are used to grow anaerobic organisms. Examples: ü Thioglycollate broth ü Robertsons Cooked Meat Medium

Mueller-Hinton agar 39

• Mueller-Hinton agar is an microbiological growth medium that is commonly used for antibiotic susceptibility testing. • Originally formulated for isolation of Neisseria species. • It is also used to isolate and maintain Neisseria and Moraxella species. 40

11/9/2020 41

THANK YOU 11/9/2020 42